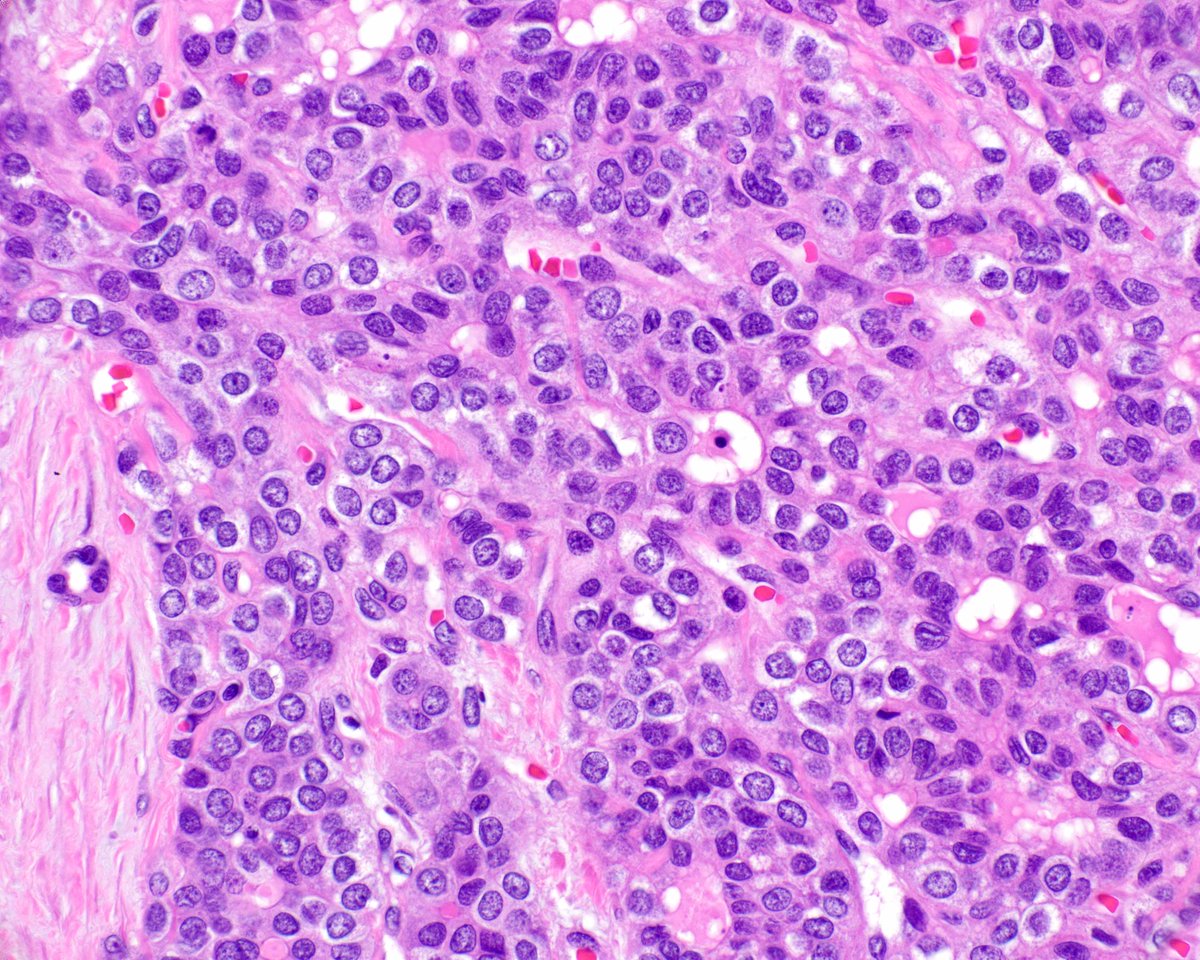
Elizabeth Montgomery, MD tweet media

Jing Di (邸菁) MD, PhD retweetledi

Final version of this article is now posted!
Granular/oncocytic lung carcinomas: what these are, and how they can cause diagnostic problems.
sciencedirect.com/science/articl…
x.com/natasharekhtma…

Natasha Rekhtman MD PhD@natasharekhtman
1/ Just out in @ModernPathology New study from our group: A distinct variant of aggressive lung carcinoma with peculiar pathologic features. We called these tumors “SAGA” (solid and granular adenocarcinoma) .. sorting them out was in fact a long and winding saga that led to some unexpected insights. 👇 modernpathology.org/article/S0893-… pubmed.ncbi.nlm.nih.gov/41580239/
English